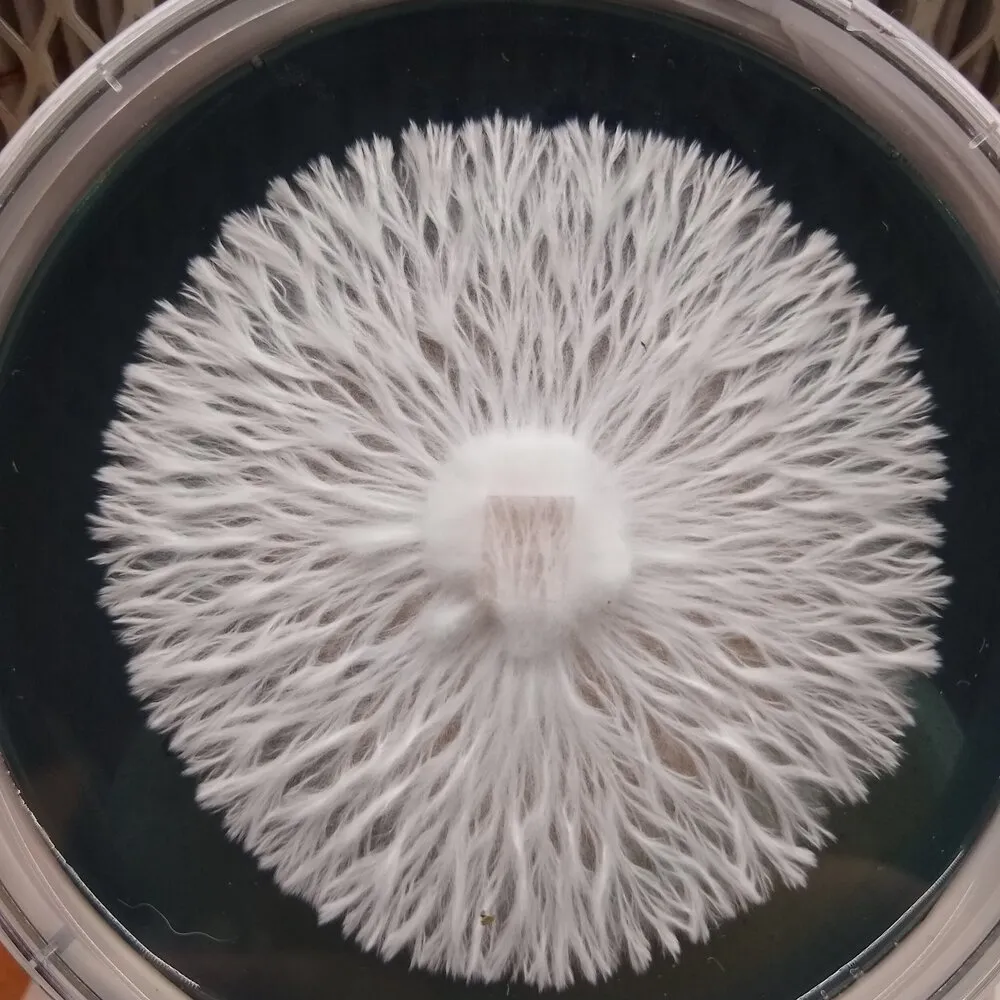

High-Quality Mushroom Spores for Collectors & Researchers
Explore a curated selection of premium mushroom spores, including iconic strains like Albino Penis Envy.
At Basidium Equilibrium, we’re committed to providing the cleanest, most reliable premium mushroom spore syringes, prints, and swabs available. Moreover, our team of passionate mycologists is dedicated to offering swift and friendly customer service, ensuring that your research and collecting needs are fully supported. we’ve been expecting you.
Our All-Time Favorite Mushroom Spores
-
 Product on saleHillbilly Pumpkin Isolated Spore SyringeOriginal price was: $25.00.$20.00Current price is: $20.00.
Product on saleHillbilly Pumpkin Isolated Spore SyringeOriginal price was: $25.00.$20.00Current price is: $20.00. -
 Product on saleManna From Heaven Albino Penis Envy Isolated Spore SyringeOriginal price was: $25.00.$20.00Current price is: $20.00.
Product on saleManna From Heaven Albino Penis Envy Isolated Spore SyringeOriginal price was: $25.00.$20.00Current price is: $20.00. -
 Product on saleSquat Mac Isolated Spore SyringeOriginal price was: $25.00.$20.00Current price is: $20.00.
Product on saleSquat Mac Isolated Spore SyringeOriginal price was: $25.00.$20.00Current price is: $20.00. -

-

-
 Product on saleAlbino Bluey Vuitton Isolated Spore SyringeOriginal price was: $25.00.$20.00Current price is: $20.00.
Product on saleAlbino Bluey Vuitton Isolated Spore SyringeOriginal price was: $25.00.$20.00Current price is: $20.00.

Adam B.
Get everything you need to start your spore collection with our exclusive bundles. Save on top-rated products when you buy as a set!
-
 Product on saleIsolated Spore Syringe Bundle 10 PackOriginal price was: $170.00.$85.00Current price is: $85.00.
Product on saleIsolated Spore Syringe Bundle 10 PackOriginal price was: $170.00.$85.00Current price is: $85.00. -
 Product on saleMushroom Magnums – Penis Envy 20-Pack BundleOriginal price was: $450.00.$250.00Current price is: $250.00.
Product on saleMushroom Magnums – Penis Envy 20-Pack BundleOriginal price was: $450.00.$250.00Current price is: $250.00. -
 Product on saleSpore Syringe Bundle – 5 PackOriginal price was: $60.00.$50.00Current price is: $50.00.
Product on saleSpore Syringe Bundle – 5 PackOriginal price was: $60.00.$50.00Current price is: $50.00.
Blog & News
Explore articles on the environmental, cultural, and scientific impact of mushrooms. If you’re a mycology enthusiast or simply curious, our blog offers expert insights and exciting discoveries.
Psilocybe Subtropicalis: The Ever-Living Mystery of Semperviva and Its Taxonomic Saga
Understanding Mushroom Genetics
Explore the fascinating world of fungal genetics and, in particular, discover how lineage tracking and mapping reveals the hidden connections between strains. By using this method, researchers can better understand the genetic makeup of various mushroom strains, thereby gaining insights into their evolution, traits, and potential uses. Furthermore, our resources provide the knowledge you need to dive into this exciting area of mycology, from research breakthroughs to practical applications.
Lineage Tracking and Mapping in Mycology

Mycelium Works
Explore the remarkable journey of mushrooms, beginning with the spore and eventually culminating in the fruiting body. Through this process, Mycelium Works uncovers the invisible networks of mycelium that weave through soil and wood, thereby sustaining ecosystems and shaping the natural world. Additionally, discover how these hidden threads connect life, store nutrients, and in fact can even outlive forests themselves.
What Is an Isolated Spore Syringe?
Basidium Equilibrium crafts isolated spore syringes from precisely bred Psilocybe genetics. These syringes showcase the pinnacle of fungal research, featuring spores that we isolate for specific traits. After years of meticulous lab work,our team suspends sterile spores in an aqueous solution to ensure optimal hydration and storage for your research needs.
Furthermore, we prepare every syringe in UPLA-filtered clean rooms, guaranteeing the highest standards of purity and quality. Each syringe contains thousands of isolated particles, carefully measured to support reliable and successful research outcomes.


Discover Our New Arrivals
We’re constantly expanding our collection, and we’re especially thrilled to introduce our latest additions. From fresh strains like Psilocybe subtropicalis to other exciting new options, our new arrivals offer unique genetics for collectors, researchers, and mycology enthusiasts. Moreover, these carefully curated spores showcase the diversity and potential of fungal genetics. Therefore, stay ahead of the curve and explore our newest spores, as they provide a rare opportunity to study and appreciate the intricacies of fungi.
What Are Mushroom Spores?
Spores are the foundation of the fungal world; tiny, dust-like particles with the power to create new life. In fact, they carry the genetic blueprint of their parent fungi, ready to spread and colonize new environments. Spores act like seeds of plants, creating the next generation of life starts with gemination. Whether you’re an educator, researcher, or enthusiast, understanding spores is the first step in unlocking the mysteries of fungi. Additionally, exploring spores helps reveal how mushrooms grow, adapt, and interact with their surroundings. Ultimately, knowledge of spores forms the gateway to deeper fungal study.







